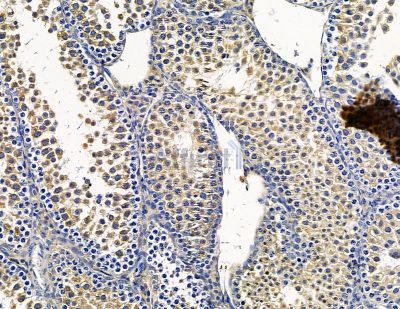
ARL6IP1 Antibody - DF15567 at 1/100 staining mouse testis tissue by IHC-P.

ARL6IP1 Antibody - #DF15567
Related Downloads
Protocols
Product Info
*The optimal dilutions should be determined by the end user. For optimal experimental results, antibody reuse is not recommended.
*Tips:
WB: For western blot detection of denatured protein samples. IHC: For immunohistochemical detection of paraffin sections (IHC-p) or frozen sections (IHC-f) of tissue samples. IF/ICC: For immunofluorescence detection of cell samples. ELISA(peptide): For ELISA detection of antigenic peptide.
Fold/Unfold
ADP ribosylation factor like 6 interacting protein; ADP-ribosylation factor-like protein 6-interacting protein 1; Aip-1; Aip1; AR6P1_HUMAN; ARL-6-interacting protein 1; ARL6 interacting protein 1; ARL6IP; Arl6ip1; ARMER; KIAA0069;
Immunogens
A synthesized peptide derived from human ARL6IP1.
Expressed in all hematopoietic cell lineages, but the highest level of expression is found in early myeloid progenitor cells. Expressed in brain, bone marrow, thymus and lung. Expressed at low level in liver, kidney and spleen. Not detected in heart.
- Q15041 AR6P1_HUMAN:
- Protein BLAST With
- NCBI/
- ExPASy/
- Uniprot
MAEGDNRSTNLLAAETASLEEQLQGWGEVMLMADKVLRWERAWFPPAIMGVVSLVFLIIYYLDPSVLSGVSCFVMFLCLADYLVPILAPRIFGSNKWTTEQQQRFHEICSNLVKTRRRAVGWWKRLFTLKEEKPKMYFMTMIVSLAAVAWVGQQVHNLLLTYLIVTSLLLLPGLNQHGIILKYIGMAKREINKLLKQKEKKNE
Research Backgrounds
Positively regulates SLC1A1/EAAC1-mediated glutamate transport by increasing its affinity for glutamate in a PKC activity-dependent manner. Promotes the catalytic efficiency of SLC1A1/EAAC1 probably by reducing its interaction with ARL6IP5, a negative regulator of SLC1A1/EAAC1-mediated glutamate transport (By similarity). Plays a role in the formation and stabilization of endoplasmic reticulum tubules. Negatively regulates apoptosis, possibly by modulating the activity of caspase-9 (CASP9). Inhibits cleavage of CASP9-dependent substrates and downstream markers of apoptosis but not CASP9 itself. May be involved in protein transport, membrane trafficking, or cell signaling during hematopoietic maturation.
Endomembrane system>Multi-pass membrane protein. Endoplasmic reticulum membrane>Multi-pass membrane protein. Endoplasmic reticulum.
Note: Predominantly localized to intracytoplasmic membranes. Preferentially localizes at the ER tubules and the edge of the ER sheets, both of which are characterized by a high membrane curvature.
Expressed in all hematopoietic cell lineages, but the highest level of expression is found in early myeloid progenitor cells. Expressed in brain, bone marrow, thymus and lung. Expressed at low level in liver, kidney and spleen. Not detected in heart.
The transmembrane domains are required for its ability to shape the endoplasmic reticulum membrane into tubules.
Belongs to the ARL6ip family.
Restrictive clause
Affinity Biosciences tests all products strictly. Citations are provided as a resource for additional applications that have not been validated by Affinity Biosciences. Please choose the appropriate format for each application and consult Materials and Methods sections for additional details about the use of any product in these publications.
For Research Use Only.
Not for use in diagnostic or therapeutic procedures. Not for resale. Not for distribution without written consent. Affinity Biosciences will not be held responsible for patent infringement or other violations that may occur with the use of our products. Affinity Biosciences, Affinity Biosciences Logo and all other trademarks are the property of Affinity Biosciences LTD.